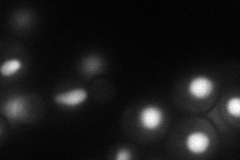
YOL115W
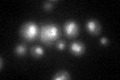
YOL115W
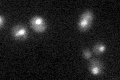
YOL115W

View description
Non-canonical poly(A) polymerase, involved in nuclear RNA degradation as a component of the TRAMP complex; catalyzes polyadenylation of hypomodified tRNAs, and snoRNA and rRNA precursors; overlapping but non-redundant functions with Trf5p
Localization:
Intensity:
Fold change:
Significance:
-
C’ GFP library in SD

nucleus30.37 -
N' NOP1pr-GFP in SD
nucleus52.9343 -
N' TEF2pr-mCherry in SD

nucleus33.7409 -
N' NATIVEpr-GFP in SD

nucleus42.5922 -
N' TEF2pr-VC and Cyto-VN in SD

punctate,nucleus36.5969 -
C’ GFP library in SD+DTT
nucleus30.350.99No -
C’ GFP library in SD+H2O2

nucleus30.210.99No -
C’ GFP library in Starvation Media
nucleus32.731.07No -
C’ GFP library on the background of Pup2-DaMP

N/A -
C’ GFP library on the background of CCT mutant

N/A0N/AYes
